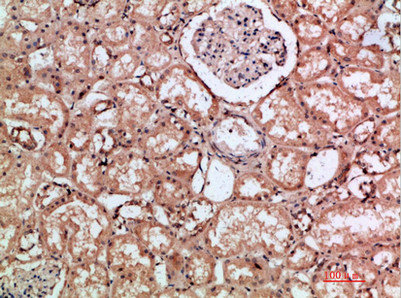

HMMR Antibody
-
中文名稱:HMMR兔多克隆抗體
-
貨號:CSB-PA495608
-
規(guī)格:¥1090
-
圖片:
-
其他:
產品詳情
-
Uniprot No.:
-
基因名:
-
別名:CD168 antibody; CD168 antigen antibody; HMMR antibody; HMMR_HUMAN antibody; Hyaluronan mediated motility receptor antibody; Hyaluronan-mediated motility receptor (RHAMM) antibody; IHABP antibody; Intracellular hyaluronic acid-binding protein antibody; MGC119494 antibody; MGC119495 antibody; OTTHUMP00000196920 antibody; Receptor for hyaluronan-mediated motility antibody; RHAMM antibody
-
宿主:Rabbit
-
反應種屬:Human
-
免疫原:Synthetic peptide from Human protein at AA range: 280-340
-
免疫原種屬:Homo sapiens (Human)
-
標記方式:Non-conjugated
-
純化方式:The antibody was affinity-purified from rabbit serum by affinity-chromatography using specific immunogen.
-
濃度:It differs from different batches. Please contact us to confirm it.
-
保存緩沖液:PBS, pH 7.4, containing 0.02% sodium azide as Preservative and 50% Glycerol.
-
產品提供形式:Liquid
-
應用范圍:WB, IHC, ELISA
-
推薦稀釋比:
Application Recommended Dilution WB 1:500-2000 IHC 1:50-300 ELISA 1:10000-20000 -
Protocols:
-
儲存條件:Upon receipt, store at -20°C or -80°C. Avoid repeated freeze.
-
貨期:Basically, we can dispatch the products out in 1-3 working days after receiving your orders. Delivery time maybe differs from different purchasing way or location, please kindly consult your local distributors for specific delivery time.
-
用途:For Research Use Only. Not for use in diagnostic or therapeutic procedures.
相關產品
靶點詳情
-
功能:Receptor for hyaluronic acid (HA). Involved in cell motility. When hyaluronan binds to HMMR, the phosphorylation of a number of proteins, including PTK2/FAK1 occurs. May also be involved in cellular transformation and metastasis formation, and in regulating extracellular-regulated kinase (ERK) activity. May act as a regulator of adipogenisis.
-
基因功能參考文獻:
- A mechanism of sense-antisense interference between HMMR and HMMR-AS1 in GBM. PMID: 29574252
- This pilot study shows, for the first time, that RHAMM may contribute to ovarian cancer disease and could potentially be used as a prognostic marker. PMID: 28954627
- The ability to enhance cell polarity through the application of this dielectrophoretic (DEP) electromagnetic field (EMF) force may offer another way to stabilize HMMR and differentially modulate its expression in cancerous and noncancerous cells. PMID: 28595038
- we found that RHAMM-specific T cells are present at vaccination sites in AML patients. Our findings implicate that we and others who are using classical mo-DCs for cancer immunotherapy are already vaccinating against RHAMM. PMID: 27659531
- RHAMM, most likely RHAMMv3 (RHAMMB), can serve as a prognostic factor for lung adenocarcinomas and a potential therapeutic target in non-small cell lung carcinoma to inhibit tumor migration PMID: 27220886
- Data show that receptor of hyaluronan-mediated motility (RHAMM) mRNA expression in breast cancer biopsies is inversely correlated with tumor grade and overall survival. PMID: 26870892
- spindle-associated RHAMM as an intrinsic regulator of male germ cell fate and as a gatekeeper preventing initiation of testicular germ cell tumors (TGCT). PMID: 27543603
- Overexpression of the hyaluronan receptor HMMR in primary LUAD was associated with an inflammatory molecular signature and poor prognosis. Attenuating HMMR in LUAD cells diminished their ability to initiate lung tumors and distant metastases. PMID: 28196904
- The present study suggests that RHAMM is a novel beta-catenin intracellular binding partner, protecting beta-catenin from degradation and supporting the nuclear translocation of this key cellular mediator PMID: 26825774
- RHAMM expression identifies an aggressive subpopulation of tumor budding cells and is an independent adverse prognostic factor for colorectal cancer patients. PMID: 26351067
- a causative link between altered function of AURKA-HMMR-TPX2-TUBG1 and breast carcinogenesis in BRCA1/2 mutation carriers PMID: 25830658
- Identify RHAMM as a critical regulator of TPX2 location/ Aurora kinase A signaling and suggest that RHAMM ensures bipolar spindle assembly and mitotic progression through the integration of biochemical and structural pathways. PMID: 24875404
- In ocular TM cells, our data suggests that the most important determinant of HA cable formation appears to be the ratio of HA chains produced by the different HAS genes. PMID: 26247678
- RHAMM might be a promising marker to identify early stage (nodal negative) patients at risk for dismal survival, who may benefit from specific adjuvant therapies. PMID: 25731190
- analysis of the role of growth factors in Hyaluronan/RHAMM interactions in mesenchymal tumor pathogenesis [review] PMID: 25081535
- Case Report: identify patient with cervical cancer expressing three HMMR mRNA variants. PMID: 24966934
- RHAMM may be implicated in severe ocular surface inflammation affecting the upper tarsal conjunctiva. PMID: 24916930
- stimulation of the E2F1-RHAMM axis in aggressive cancer cells is of high clinical significance PMID: 25042645
- HMMR overexpression promotes GSC self-renewal. PMID: 24710409
- RHAMM plays a crucial role in mediating progression of muscle-invasive bladder cancer and recommends RHAMM for further evaluation as a prognostic marker or therapeutic target in bladder cancer therapy. PMID: 24069434
- RHAMM transcription is regulated via YAP in a pathway involving mevalonate and Hippo that modulates breast cancer cell motility PMID: 24367099
- Suggest that detection of upregulated RHAMM expression in an ossifying fibroma assists with differential diagnosis and has a key role in elucidation of its pathophysiology. PMID: 23382057
- Data indicate that the sensitivity of cell-lines with amplification of AURKA depends upon the activity of the kinase, which correlates with the expression of the regulatory gene products TPX2 and HMMR/RHAMM. PMID: 23328114
- RHAMM does not fulfill the criteria of an ideal target antigen for immunotherapy of acute myeloid leukemia. PMID: 22532518
- Hyaluronan (HA) interacting proteins RHAMM and hyaluronidase impact prostate cancer cell behavior and invadopodia formation in 3D HA-based hydrogels. PMID: 23166824
- Hyaluronan receptors in the human ocular surface: a descriptive and comparative study of RHAMM and CD44 in tissues, cell lines and freshly collected samples. PMID: 22095138
- TCR-transgenic lymphocytes specific for HMMR/Rhamm limit tumor outgrowth in vivo. PMID: 22371883
- study depicts a molecular mechanism involving BRCA1 and RHAMM that regulates apicobasal polarity and, when perturbed, may increase risk of breast cancer PMID: 22110403
- RHAMM/HA interaction regulates fibrosarcoma cell adhesion via the activation of FAK and ERK1/2 signaling pathways PMID: 21914806
- Nodular basal cell carcinoma is associated with increased levels of hyaluronic acid concomitant with upregulation of gene expression of HAS3, HYAL3 and RHAMM, when compared with normal adjacent skin. PMID: 20849445
- RHAMM not only represents a promising leukemia-associated antigens with specific T-cell responses in acute myeloid leukemia but, if assessed in situ on blasts, also a probable prognostic factor PMID: 21274712
- tumor expression can be used as a prognostic marker of gastric cancer PMID: 21435222
- study reports the new machinery by which RHAMM/ERK interaction induces the proliferative activity of cementifying fibroma cells via a specific signaling pathway through the CD44-EGFR axis PMID: 20956971
- RHAMM regulates the ciliary differentiation-promoting effect of retinoic acid on respiratory epithelial cells. PMID: 20619784
- coexpression of any of the CD44v with the receptor for hyaluronic acid-mediated motility (RHAMM, CD168) identifies a subgroup of DLBCL patients with a very poor prognosis, independent of the International Prognostic Index PMID: 19857547
- Hyaluronate receptors mediate glioma cell migration and proliferation. The expression of the HA-receptors, CD44, and RHAMM, is virtually ubiquitous amongst glioma cell lines, and glioma tumor specimens. PMID: 11716065
- RHAMM is an immunogenic antigen expressed in leukemias and solid tumors and might be a potential target structure for cellular immunotherapies and antibody therapies. RHAMM is not expressed in normal tissues except for testis, placenta, thymus. PMID: 12225794
- Increased RHAMM expression may enhance and improve the invasion and metastasis of endometrial carcinomas PMID: 12712331
- Augmentation of RHAMM expression within human cancers, including myeloma, can directly affect centrosomal structure and spindle integrity and potentially modulate apoptotic and cell cycle progression pathways. PMID: 15705883
- The overall results suggest that IHABP regulates the subcelluar localization of Bach1 in order to fine-tune transactivation of Bach1 target genes such as heme oxygenase-1. PMID: 15809329
- RHAMM/CD168 R3-peptide (ILSLELMKL)-specific T-cell responses in chronic myeloid leukemia [CML] patients were demonstrated; vaccination strategies inducing such RHAMM-R3-directed effector T cells might enhance specific immune responses against CML cells. PMID: 17157168
- an effect of CD44 on tumor cell motility may depend in part on its ability to partner with additional proteins, such as cell surface Rhamm. PMID: 17392272
- These data suggest that high molecular form hyaluronan is broken down by reactive oxygen species to form low-molecular-weight fragments that signal via RHAMM and RON to stimulate beat frequency. PMID: 17395888
- RHAMM is expressed in embryhonic stem cells (ESC) and has an important role in maintenance of ESC pluripotency and proliferation. PMID: 17872502
- Overexpression of HMMR is associated with breast cancer PMID: 17922014
- RHAMM-R3 peptide vaccination induced both immunologic and clinical responses, and therefore RHAMM constitutes a promising target for further immunotherapeutic approaches PMID: 17978170
- Androgen receptor regulates CD168 expression and signaling in prostate cancer PMID: 18174258
- The unconventional export of proteins such as RHAMM is a novel process that modifies the roles of tumor suppressors and promoters, such as BRCA1 and CD44, and might provide new targets for therapeutic intervention. PMID: 18354082
- Results suggested that in oral squamous cell carcinoma RHAMM expression may be correlated with tumor aggressiveness. PMID: 18425326
- The combined phenotype of RHAMM and p21 expression is an invaluable independent prognostic immunohistochemical profile in microsatellite instability-high colorectal cancer. PMID: 18559599
顯示更多
收起更多
-
亞細胞定位:Cell surface. Cytoplasm. Cytoplasm, cytoskeleton, spindle.
-
組織特異性:Expressed in testis. Expressed in the breast.
-
數(shù)據(jù)庫鏈接:
Most popular with customers
-
-
YWHAB Recombinant Monoclonal Antibody
Applications: ELISA, WB, IHC, IF, FC
Species Reactivity: Human, Mouse, Rat
-
Phospho-YAP1 (S127) Recombinant Monoclonal Antibody
Applications: ELISA, WB, IHC
Species Reactivity: Human
-
-
-
-
-